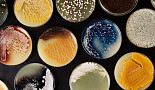
'세포 엔지니어링' 긴코,

검색
검색어를 입력하세요.
-
메디픽셀, 시리즈A 65억.."AI 솔루션 역량 강화"
윤소영 기자 2021-05-13 15:47
-
엠디뮨, 경북대서 CDV 관련 특허기술 L/I
서윤석 기자 2021-05-13 15:34
-
'세포 엔지니어링' 긴코, "150억弗 밸류" SPAC 상장
윤소영 기자 2021-05-13 14:42
-
피노바이오, 'DNMT 저해제' 난소암 "호주 1/2상 승인"
윤소영 기자 2021-05-13 14:00
-
'노벨상·카이트 멤버' 아피아, 동종 'CAR-iNKT' 전략은?
김성민 기자 2021-05-13 11:11
-
아나패스, 카나프와 신약 전반 '전임상 개발' MOU
김성민 기자 2021-05-13 10:17
-
릴리, MiNA와 新모달리티 'saRNA' "12.5억弗 딜"
서윤석 기자 2021-05-13 09:20
-
'항노화' 메디스팬, 시리즈A 65억.."파이프라인 확대"
김성민 기자 2021-05-13 08:59
-
누발란트, 시리즈B 1.35억弗..”ROS1∙ALK저해제 개발”
노신영 기자 2021-05-13 07:19
-
부광약품, '코로나19' 2상 "주평가변수 미충족"
서윤석 기자 2021-05-12 19:03
-
셀트리온, 1Q 영업이익 2077억..전년대비 72.8%↑
서윤석 기자 2021-05-12 16:59
-
모더나 창업팀 "3년 준비끝에" eRNA '라롱드' 출범
김성민 기자 2021-05-12 14:02
-
지놈앤컴퍼니 자회사 사이오토, 'ABT 플랫폼' 논문
윤소영 기자 2021-05-12 13:15
-
씨젠, 1Q 영업이익 1939억..전년대비 338%↑
서윤석 기자 2021-05-12 12:30
-
IMB Dx, 시리즈B 208억..”ctDNA 암진단 개발”
서윤석 기자 2021-05-12 11:49